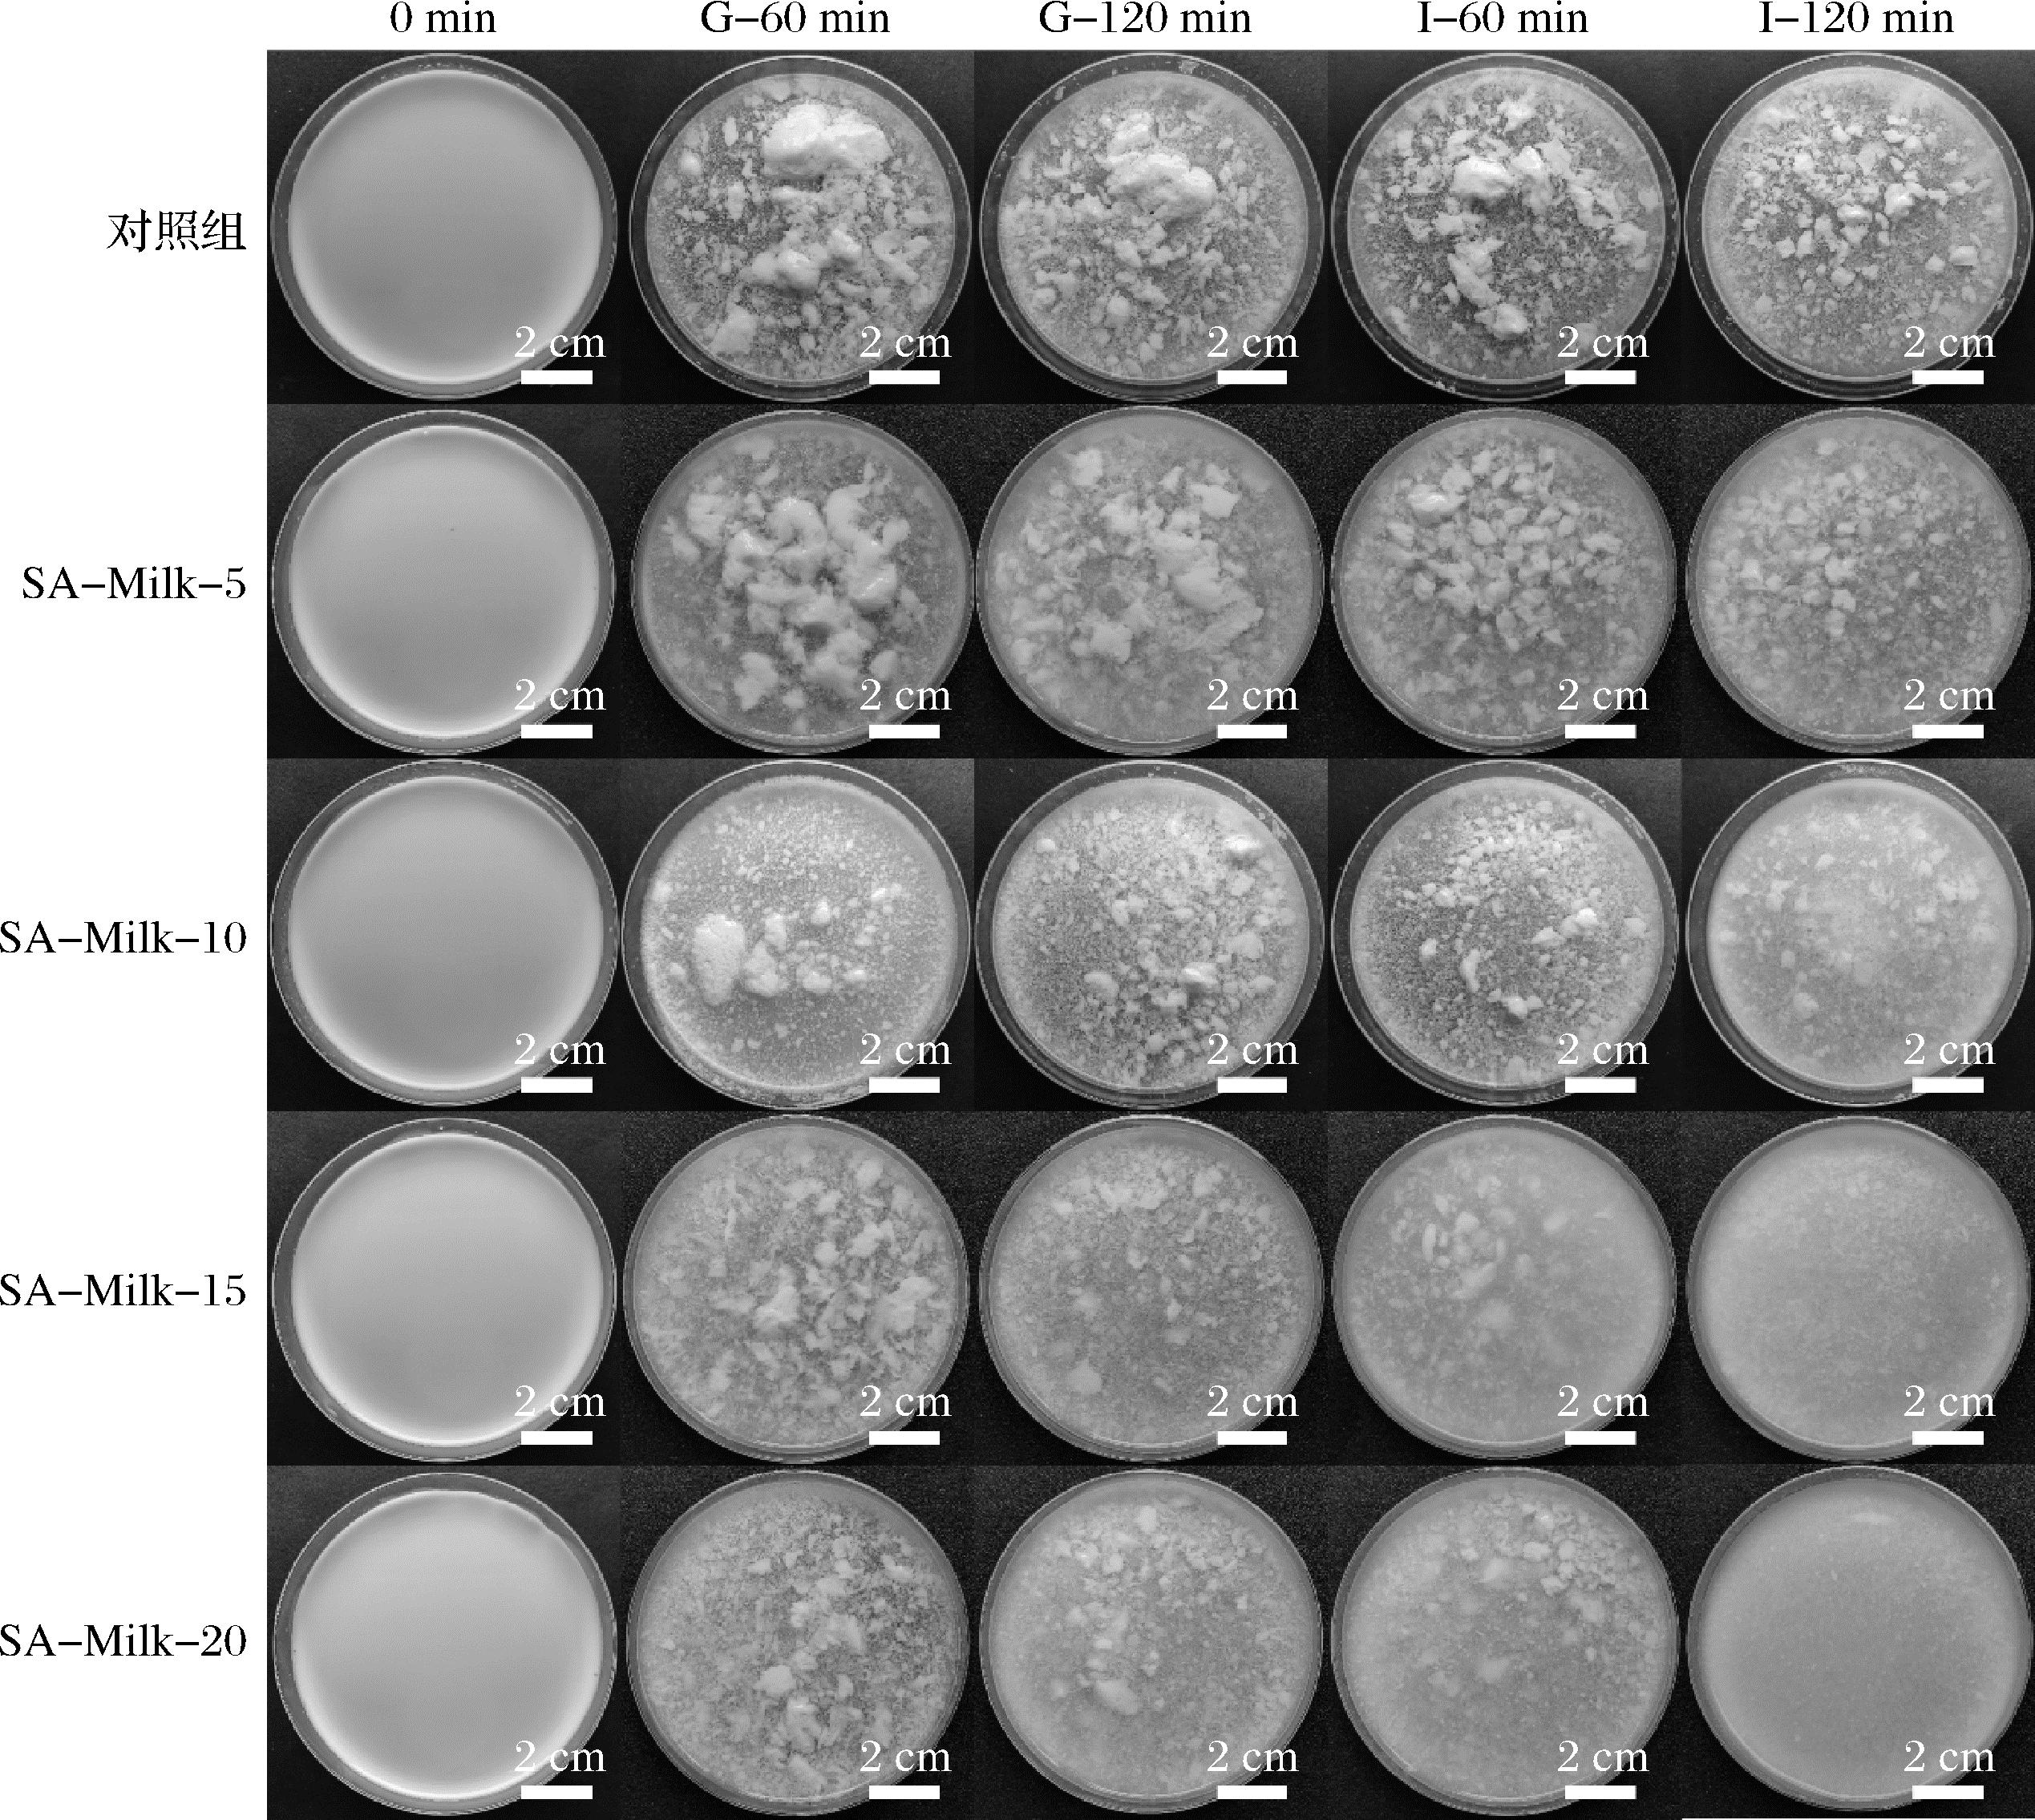

在预期寿命延长与生育率持续下降的双重驱动下,全球人口老龄化问题日益加剧,进而对公共卫生体系与营养供给提出了前所未有的挑战。根据联合国标准,当65岁及以上人口占比达到或超过7%时,即可视为进入老龄化社会。最新普查数据显示,中国老年人口占比已超过15%,且全球范围内呈现出相似趋势[1]。在此背景下,老年群体的消化健康与营养摄入问题日益凸显。随着年龄增长,胃肠功能逐渐衰退,主要表现为胃酸分泌减少、肠道蠕动减缓及食糜通过时间延长,直接导致消化功能障碍[2]。
在诸多营养挑战中,膳食纤维摄入不足尤为突出。大量研究表明,老年人实际的膳食纤维摄入量远低于国际推荐水平:欧洲建议成年人每日摄入25~30 g膳食纤维,但大多数老年人难以达标[3];中国老年人群日均摄入量仅为9.7 g,尚不足推荐摄入量的40%[4]。长期的膳食纤维摄入不足与胃肠功能紊乱、心血管疾病及糖代谢异常等健康风险密切相关[3,5-6]。因此,开发既具备高营养价值又适应老年人消化特点的膳食纤维食品已成为迫切需求。
牛奶作为一种优质的功能性食品,富含蛋白质、钙及多种必需维生素,因而深受老年人群体的欢迎。然而,牛奶本身膳食纤维含量有限,无法满足老年人对纤维的摄入需求。因此,在牛奶中添加合适类型的膳食纤维被视为改善其营养结构的有效手段。已有研究表明,阴离子型膳食纤维可改善乳液分散性和调节营养物质的消化特性,对提升营养吸收具有重要作用,尤其对纤维摄入不足的老年人更具现实意义。QIN等[7]发现海藻酸钠(sodium alginate,SA)分子中的羧基负电荷可与乳液胶体颗粒间产生静电排斥作用,显著增强体系电荷强度,进而调控脂质消化过程;ZHANG等[8]研究表明,阴离子多糖与豆类蛋白质的相互作用提高了乳液的稳定性;SHI等[9]报道,阴离子膳食纤维能够抑制胃期乳液聚集,其中卡拉胶促进了乳液脂质的消化。然而,现有研究多聚焦于成人胃肠环境及脂质消化机制,对于老年人特有的胃肠生理条件,阴离子膳食纤维如何影响乳制品中蛋白质的消化吸收,相关研究尚不充分。
已有研究表明,胃蛋白凝乳的形成与蛋白酶解效率密切相关[10],且该过程在老年人消化环境中会发生显著变化。因此,探索不同质量浓度梯度下阴离子膳食纤维对凝乳形成及其消化动力学的影响,有助于揭示其调控蛋白质生物利用度的潜力,为改善老年人蛋白质吸收效率提供新思路。因此,本研究选取典型阴离子膳食纤维——SA,在模拟老年人胃肠消化条件下,系统探讨其不同质量浓度对牛奶消化行为的影响。重点揭示其对牛奶胃凝乳特性及蛋白质水解动力学的调控机制,旨在为老年乳制品的膳食纤维配方优化提供理论依据,并为定制化老年营养食品的开发奠定科学基础。
1 材料与方法
1.1 材料与试剂
超高温灭菌乳,内蒙古蒙牛乳业(集团)股份有限公司;SA(取代度98%),阿拉丁试剂(上海)有限公司;盐酸,永华化学科技股份有限公司;胃蛋白酶、胰酶,美国Sigma-Aldrich公司;生物聚合物溶液使用Milli-Q超纯水,上海康锐分析仪器有限公司配制(Heal Force纯水系统)。
1.2 仪器与设备
GZX-GF101-4-BS-Ⅱ电热恒温鼓风干燥箱,上海跃进医疗器械有限公司;HHS-4S水浴锅,上海康路仪器有限公司;AL204电子天平,梅特勒-托利多有限公司;MP511型pH计,上海三信仪器有限公司;MAXQ6000摇床,美国赛默飞世尔科技公司;UV-1800紫外-可见分光光度计,上海Mapada仪器有限公司;KNX2100旋转流变仪,马尔文仪器有限公司。
1.3 实验方法
1.3.1 SA强化牛奶的配制
基于对市售膳食纤维强化牛奶产品的全面调查,膳食纤维的常见添加质量浓度为5~20 mg/mL。因此,本研究添加量设定为5、10、15、20 mg/mL。称取0.05、0.10、0.15、0.20 g SA,分别加入4份10 mL超高温灭菌乳中。混合物于25 ℃下使用磁力搅拌器搅拌至SA完全溶解,制得以下SA强化牛奶(SA-Milk)样品:5 mg/mL SA-Milk(SA-Milk-5)、10 mg/mL SA-Milk(SA-Milk-10)、15 mg/mL SA-Milk(SA-Milk-15)以及20 mg/mL SA-Milk(SA-Milk-20)。未添加SA的超高温灭菌乳作为对照组。
1.3.2 模拟老年人胃肠条件下牛奶体外消化
参照MENARD等[11]建立的方法,构建适用于65岁及以上老年人的静态体外消化模型,对模拟胃液(simulated gastric fluid,SGF)和模拟肠液(simulated intestinal fluid,SIF)的配方进行针对性优化,以更贴合老年人群的胃肠生理特征(如表1所示)。在该模型中,对含有不同质量浓度SA的牛奶及未添加SA的对照组进行了体外消化实验,具体步骤如下。
表1 模拟成人与老年人胃肠消化条件的参数设定对比
Table 1 Comparison of gastrointestinal digestion parameters between adult and elderly models

消化阶段消化参数成人模型老年人模型胃阶段搅拌速率/(r/min)200 100SGF参见BRODKORB等[13]的配方与成人模型相同pH值3.03.7胃蛋白酶活性/(U/mL)2 000 1 200小肠阶段搅拌速率/(r/min)200 100 SIF参见BRODKORB等[13]的配方Ca2+浓度为1 mmol/L,其余与成人模型相同pH值7.07.0胰酶活性/(U/mL)100 80胆盐浓度/(mmol/L)106.7
首先,将10 mL牛奶与等体积新鲜配制的SGF混合,并用3 mol/L HCl溶液将体系pH调整至3.7。参照MENARD等[11]的方法,添加胃蛋白酶使其最终活性为1 200 U/mL(成人模型中胃蛋白酶活性为2 000 U/mL),添加 CaCl2,使其最终浓度为 0.075 mmol/L。混合物在37 ℃、100 r/min条件下振荡反应120 min,以模拟老年人胃部消化过程(成人模型中搅拌速率为200 r/min)。随后将胃消化后的食糜与等体积SIF混合,用1 mol/L NaOH溶液将体系pH调整至7.0,启动肠消化。向体系中加入胰酶使其最终活性为80 U/mL(成人模型中为100 U/mL),添加 CaCl2和胆盐使其最终浓度分别为1、6.67 mmol/L(成人模型中分别为0.3、10 mmol/L)[11-12]。混合物继续在37 ℃、100 r/min条件下振荡120 min,以模拟小肠阶段的消化过程。
1.3.3 消化样品外观测定
在模拟老年人体外消化过程中,分别于消化前及胃消化60 min(G-60 min)、120 min(G-120 min)和肠消化60 min(I-60 min)、120 min(I-120 min)时间点采集对照组牛奶和4组SA-Milk的消化样品,样品转移至直径10 cm培养皿中,使用相机拍摄各时间点蛋白凝乳形态。拍摄全程培养皿温度维持37 ℃。
1.3.4 蛋白凝乳含水率及粒径测定
在模拟老年人体外消化过程中分别以胃消化60、120 min和肠消化60、120 min为时间点,采集对照组牛奶和4组SA-Milk的消化样品。参照YE等[14]的方法,样品经SGF和去离子水冲洗以去除表面结合的胃蛋白酶和其他可溶性组分,随后通过1 mm孔径筛网分离蛋白凝乳与水相。立即称量凝乳总质量,并于105 ℃真空干燥箱中干燥12 h至恒重。含水率以凝乳总质量与干质量差值占凝乳总质量的百分比表示。粒径分析参照JALABERT-MALBOS等[15]方法:将凝乳依次通过6、5、4、3、2、1 mm孔径筛网(共6层),经SGF和去离子水冲洗去除残留消化液及其他可溶性组分。轻叩筛网确保颗粒充分分离后,置于37 ℃培养箱中干燥6 min。称量各筛网截留凝乳质量,计算不同粒径区间凝乳的质量百分比。
1.3.5 流变特性测定
在模拟老年人体外消化过程中,分别于消化前、胃消化60与120 min、肠消化60与120 min这5个时间点采集对照组牛奶与4组SA-Milk的消化样品(各取1.2 mL)。参照IQBAL等[16]、COFRADES等[17]的方法,在37 ℃恒温条件下,使用直径为40 mm的锥板夹具(CP4/40),设置剪切速率0.1~100 s-1,测定表观黏度随剪切速率的变化关系,以表征各样品在体外消化前后的流动特性。此外,选取剪切速率为1 s-1的条件,从各时间点对应的流动曲线中提取样品的表观黏度值,用于进一步比较不同处理组在消化过程中的流变特性趋势。
1.3.6 蛋白质消化率测定
在模拟老年人体外消化过程中,分别于消化前(0 min)以及消化15、30、60、120、135、150、180、240 min时间点采集对照组牛奶与4组SA-Milk的消化样品,用于蛋白水解度的测定。取样后立即置于冰水浴中,按体积比4∶1加入0.4 mol/L三氯乙酸溶液终止消化反应并沉淀不溶性蛋白[18]。随后于4 ℃、10 000 r/min条件下离心10 min,取上清液经0.22 μm PVDF针式滤器过滤。将400 μL上清液与3 mL 邻苯二甲醛试剂充分混合,振荡反应2 min,使用紫外分光光度计在340 nm波长处测定吸光度。以0~100 mg/L的丝氨酸标准溶液绘制标准曲线[19]。
蛋白水解度按公式(1)~公式(3)计算,用以评估肽键断裂比例:
丝氨酸![]()
(1)
(2)
蛋白水解度![]()
(3)
式中:OD,340 nm波长处的吸光度;m,样品质量,g;W,样品中蛋白质含量,%;0.951 6,校正系数,单位mmol/L;h,水解肽键数量;α和β分别是α-NH2与β-NH2的平均解离度,对应丝氨酸标准曲线的斜率与截距[20];丝氨酸(—NH2),通过标准曲线换算得到的丝氨酸氨基浓度;htot,每克蛋白质所含的肽键总数,其中乳清蛋白取值8.8 mmol/g,酪蛋白为8.2 mmol/g[18]。
1.4 统计分析
所有实验测定均至少重复2次,结果以“平均值±标准差”表示。实验数据的显著性分析采用单因素方差分析(ANOVA),并使用Tukey事后检验进行多重比较,以获得更可靠的显著性差异判定(P≤0.05)。
2 结果与讨论
2.1 消化样品表观图像
如图1所示,消化前,所有牛奶样品均呈均一乳白色液体,未观察到可见颗粒,表明体系具有良好的分散性与乳液稳定性。经过胃消化60 min后,所有样品中均出现明显的蛋白质聚集现象。这主要是由于胃酸诱导酪蛋白胶束表面电荷重新分布,羧基质子化生成羧酸,削弱了胶束间的静电斥力,从而促使蛋白质聚集并形成较大凝集体[21]。同时,胃蛋白酶在酸性环境下特异性水解酪蛋白(尤其是κ-酪蛋白)的肽键,破坏了胶束结构的完整性,使释放出的较小蛋白质片段通过疏水作用进一步聚集[22]。胃消化120 min时,随胃内容物的机械搅拌与胃蛋白酶持续水解作用,对照组牛奶样品中的蛋白质凝乳相较于60 min时有所减少,SA-Milk样品中的凝乳体积亦明显减少,且大颗粒聚集体显著减小。进入肠消化阶段,所有牛奶样品中的蛋白质凝乳进一步减少,尺寸明显缩小,这与小肠阶段模拟蠕动带来的机械搅拌及胰蛋白酶对蛋白质的持续水解密切相关。
图1 模拟老年人胃肠消化过程中牛奶样品的外观图像
Fig.1 Appearance images of milk digesta during in vitro digestion under simulated elderly gastrointestinal conditions
在相同消化时间点下,所有SA-Milk样品的蛋白质凝乳尺寸和大聚集体持续时间均显著低于对照组牛奶,且该抑制效应随SA质量浓度由5 mg/mL增至20 mg/mL 逐步增强,这一趋势贯穿整个胃肠消化过程。其主要原因在于SA兼具良好的水溶性与增稠性,可作为稳定剂有效抑制蛋白质的过度聚集[23]。此外,SA分子带有阴离子电荷,可通过静电排斥作用进一步促进乳蛋白的分散,从而降低蛋白质凝集程度[7]。
2.2 蛋白凝乳质量变化
在整个消化过程中,所有牛奶样品均出现不同程度的蛋白质凝乳,且凝乳质量随消化时间延长总体呈下降趋势。在胃消化60 min时,对照组牛奶的蛋白凝乳质量为(6.39±0.68) g,而各SA-Milk样品的凝乳质量均低于对照组,分别为:SA-Milk-5:(5.80±0.11) g,SA-Milk-10:(3.86±0.71) g,SA-Milk-15:(3.70±0.62) g,SA-Milk-20:(2.62±0.61) g。至胃消化120 min时,所有SA-Milk的凝乳质量相比60 min均有所下降,分别为:SA-Milk-5:(5.36±0.83) g,SA-Milk-10:(3.76±0.88) g,SA-Milk-15:(3.58±0.75) g,SA-Milk-20:(2.46±0.58) g;对照组牛奶凝乳质量为(5.63±0.53) g,较60 min时减少了0.76 g。由图1和图2可知,胃消化阶段对照组牛奶的大颗粒凝乳在机械搅拌下更易破碎,导致凝乳质量下降速率高于SA-Milk样品,尽管如此,其凝乳质量仍高于各SA-Milk组。

a-凝乳质量;b-凝乳含水率
图2 模拟老年人胃肠消化过程中牛奶样品的蛋白凝乳特性
Fig.2 Clot properties of milk samples during in vitro digestion under simulated elderly gastrointestinal conditions
注:组内不同字母表示数据之间差异显著(P<0.05)(下同)。
进入肠消化阶段后,各组样品的凝乳质量均显著下降。肠消化60 min时,对照组牛奶的凝乳质量为(3.82±0.76) g,较胃消化末期减少1.81 g;SA-Milk-5、SA-Milk-10、SA-Milk-15和SA-Milk-20的凝乳质量分别为(3.21±0.61)、(2.77±0.97)、(1.05±0.21)、(0.85±0.41) g,其中SA-Milk-10降低了0.99 g,其余样品均下降超过1.5 g。肠消化结束时(120 min),对照组牛奶的凝乳质量仍最高[(2.78±0.50) g],较60 min时下降1.04 g。相比之下,SA-Milk-5和SA-Milk-10的凝乳质量较60 min时分别降低1.36 g和1.56 g,而SA-Milk-15和SA-Milk-20的降幅相对较小(分别为0.27 g和0.30 g),这与其在肠消化60 min后已基本失去大颗粒凝乳有关,后续破碎和水解速率减缓。
总体来看,相同消化时间点下,所有SA-Milk样品的凝乳质量均显著低于对照组牛奶,且凝乳质量随SA质量浓度升高而逐步降低。这一质量浓度依赖效应贯穿胃肠消化全程,主要归因于SA的增稠特性及其所带负电荷产生的静电排斥作用,有助于抑制乳蛋白的过度聚集[7, 23]。该结果与图1所示的宏观样品形态完全一致,进一步验证了SA在调控牛奶蛋白聚集行为中的作用机制。
如图2-b所示,胃消化60 min时,所有组别的蛋白凝乳含水率均高于80%,组间无显著差异。随着消化过程推进,蛋白凝乳含水率呈波动下降趋势,至肠消化120 min时均降至80%以下,较胃消化60 min降幅约为7%~12%。该现象主要因为凝乳在消化过程中的破碎与酶解导致其内部网络结构被破坏,持水能力下降所致。同时,各组样品在相同时间点的凝乳含水率与对照组相比均无显著差异。
2.3 凝乳粒径
如图3、图4所示,胃消化60 min时所有牛奶样品均出现蛋白质聚集。对照组牛奶消化样品的主峰粒径区间为4~5 mm(占比32.64%),而SA-Milk组的同粒径凝乳占比均显著低于对照组,分别为SA-Milk-5(20.03%)、SA-Milk-10(4.03%)、SA-Milk-15(0%)以及SA-Milk-20(0%)。所有SA-Milk组样品的主峰区间均位于2~3 mm,其占比分别为SA-Milk-5(31.07%)、SA-Milk-10(43.23%)、SA-Milk-15(49.64%)及SA-Milk-20(47.00%),显著高于对照组的同粒径凝乳占比(20.78%)。以上数据表明对照组牛奶消化样品的大粒径凝乳占比最高而小粒径占比最低,与胃消化60 min牛奶样品的形态特征相符。值得注意的是,SA-Milk组中2~3 mm凝乳占比未随质量浓度升高持续增加(SA-Milk-15:49.64%>SA-Milk-20:47.00%),此现象源于SA-Milk-20样品1~2 mm粒径占比(45.33%)显著高于SA-Milk-15(36.91%),故不可直接推断SA-Milk-15的蛋白质聚集程度更低。此时凝乳平均粒径呈质量浓度依赖性递减,对照组牛奶消化样品的凝乳平均粒径最大[(3.45±0.14) mm],高于SA-Milk组[SA-Milk-5:(3.02±0.06) mm;SA-Milk-10:(2.49±0.10) mm;SA-Milk-15:(2.27±0.14) mm;SA-Milk-20:(2.12±0.30) mm],该质量浓度依赖关系与胃消化60 min牛奶样品的形态特征相符。

a-胃消化60 min;b-胃消化120 min;c-肠消化60 min;d-肠消化120 min
图3 模拟老年人胃肠消化过程中牛奶凝乳的粒径分布
Fig.3 Particle size distribution of milk clots during in vitro digestion under simulated elderly gastrointestinal conditions

图4 消化过程中牛奶凝乳的平均粒径
Fig.4 Average particle size of milk clots during in vitro digestion
胃消化120 min时,对照组牛奶消化样品的主峰迁移至2~3 mm,占比为31.58%,同时1~2 mm与5~6 mm区间比例均上升,表明凝乳同时存在解聚与聚集现象。SA-Milk-5和SA-Milk-10消化样品的主峰维持在2~3 mm,占比分别为38.71%和47.04%,同时1~2 mm占比上升而3~6 mm下降,表明解聚占主导。SA-Milk-15和SA-Milk-20消化样品的主峰迁移至1~2 mm,占比分别为41.56%和51.60%,2~6 mm占比下降,证实解聚占主导。此时凝乳平均粒径维持浓度依赖性递减规律,对照组牛奶消化样品的凝乳平均粒径最大[(3.15±0.14) mm],高于SA-Milk组[(SA-Milk-5:(2.77±0.19) mm;SA-Milk-10:(2.32±0.18) mm;SA-Milk-15:(2.12±0.16) mm;SA-Milk-20:(2.01±0.21) mm],该浓度依赖关系与胃消化120 min牛奶样品的形态特征相符。
肠消化阶段,所有样品3~6 mm粒径区间占比均下降而1~3 mm粒径区间占比均上升,表明解聚占主导,与肠消化阶段牛奶样品的形态特征相符。肠消化结束时,对照组牛奶消化样品的主峰为2~3 mm,占比为39.43%。SA-Milk组主峰均位于1~2 mm,占比分别为SA-Milk-5(60.13%)、SA-Milk-10(84.22%)、SA-Milk-15(99.35%)以及SA-Milk-20(99.60%)。肠消化结束时,对照组牛奶消化样品的凝乳平均粒径最大[(2.38±0.11) mm],高于SA-Milk组[SA-Milk-5:(2.02±0.09) mm;SA-Milk-10:(1.67±0.08) mm;SA-Milk-15:(1.51±0.01) mm;SA-Milk-20:(1.50±0.01) mm],与肠消化120 min牛奶样品的形态特征相符。
2.4 流变特性
如图5所示,消化前、胃消化阶段及肠消化60 min,所有样品的表观黏度随剪切速率提高而单调下降,呈现剪切变稀趋势。肠消化120 min时,对照组牛奶持续表现剪切稀释行为。SA-Milk-5、SA-Milk-10和SA-Milk-15在低剪切区(0~40 s-1)呈剪切变稀趋势,而在高剪切区(40~100 s-1)表观黏度趋近恒定值,表明此时样品为带屈服平台的假塑性流体,在低剪切区凝胶网络碎片在剪切下发生取向解离,表观黏度下降;当剪切速率超越临界值,胶束的破坏-重组达到平衡,布朗运动主导的动力学响应取代网络弹性,使黏度收敛于η∞;SA-Milk-20的平台区起始剪切速率右移至60 s-1,归因于质量浓度更高的SA通过疏水作用增强胶束交联强度,需更高剪切速率触发动态平衡。

a-初始样品;b-胃消化60 min;c-胃消化120 min;d-肠消化60 min;e-肠消化120 min;f-固定剪切速率1 s-1下的表观黏度
图5 模拟老年人胃肠消化过程中牛奶样品的稳态剪切黏度变化
Fig.5 Steady shear viscosity of milk samples during in vitro digestion under simulated elderly gastrointestinal conditions
对比不同的消化阶段,所有牛奶的胃期样品黏度均较消化前的牛奶样品呈现显著上升趋势,这主要归因于胃期蛋白凝乳的形成导致流动阻力增大,蛋白凝乳的形态、质量与粒径分析已证实该机制,直观反映了消化过程中蛋白质结构变化对流变特性的影响。进入肠消化阶段,由于胰蛋白酶活性增强及pH升高促进了蛋白凝乳的破碎与水解,黏度呈现渐进式下降趋势。该现象与前文肠消化期蛋白凝乳的形态崩解、质量减轻及粒径缩减的结果相吻合。
对比不同的牛奶样品,在固定剪切速率1 s-1条件下,消化前SA-Milk的表观黏度均高于对照组牛奶[(0.09±0.02) Pa·s],且呈现质量浓度依赖性增长:[SA-Milk-5(0.28±0.11) Pa·s、SA-Milk-10(0.91±0.40) Pa·s、SA-Milk-15(2.78±0.52) Pa·s和SA-Milk-20(3.86±0.67) Pa·s],此梯度变化与SA的增稠效应及其与钙离子形成的弱凝胶结构密切相关。在胃消化60 min时,所有SA-Milk的黏度均低于对照组牛奶[(8.73±0.96) Pa·s],该现象与消化前的趋势不一致,这归因于SA的分散效应抑制蛋白质聚集,其阴离子特性通过电荷排斥作用促进乳蛋白分散,抑制胃期蛋白凝乳形成,减小凝乳的质量与粒径,从而降低流动阻力[7, 23]。值得注意的是,当SA质量浓度在0~15 mg/mL时,胃消化60 min时的牛奶样品黏度随质量浓度升高而下降:对照组牛奶[(8.73±0.96) Pa·s]>SA-Milk-5[(6.86±1.39) Pa·s]>SA-Milk-10[(1.86±0.31) Pa·s]>SA-Milk-15[(1.19±0.18) Pa·s];但当质量浓度≥ 15 mg/mL后,黏度转而上升,SA-Milk-20样品黏度达(2.50±0.37) Pa·s,揭示了15 mg/mL为质量浓度效应的关键转折点,该黏度趋势在胃消化120 min及肠消化阶段持续存在。
消化结束时,黏度排序为:对照组牛奶[(1.06±0.13) Pa·s]>SA-Milk-5[(0.73±0.18) Pa·s]>SA-Milk-20[(0.51±0.02) Pa·s]>SA-Milk-10[(0.15±0.01) Pa·s]>SA-Milk-15[(0.04±0.02) Pa·s]。以上结果表明,消化过程中SA对牛奶样品黏度的影响始终呈现质量浓度依赖性双相特征:在低质量浓度区间(<15 mg/mL),牛奶消化样品黏度随质量浓度升高而下降,此时SA的分散效应占主导,通过静电排斥作用有效抑制蛋白质聚集,降低凝乳的质量与粒径[7, 23],而此质量浓度下SA的增稠作用及其与钙离子构建的离子交联网络尚未形成稳定结构,不足以显著增加样品的体系黏度[7]。当质量浓度超过临界阈值(≥15 mg/mL)时,牛奶消化样品黏度随质量浓度升高而上升,此时SA分子链缠结密度增加,且与钙离子构建了较为稳定的弱凝胶网络,致使消化样品表观黏度增加[7]。
2.5 蛋白质水解率
如图6所示,随着消化时间延长,所有样品的蛋白质水解率均持续上升。在胃消化阶段,水解速率整体较为缓慢,这主要归因于老年人胃消化过程中蛋白质聚集形成的空间位阻效应,显著增加了胃蛋白酶与底物的接触难度[24];同时胃蛋白酶识别与切割肽键的特异性较低,主要将可溶性蛋白质水解为多肽片段,仅生成少量游离氨基酸[25],进一步延缓水解速率。进入肠道消化阶段后,蛋白质水解率显著提升,此现象源于胰蛋白酶水解作用的专一性以及蛋白凝乳结构的崩解,二者协同促进蛋白质的深度水解[25]。

图6 模拟老年人体外消化过程中牛奶蛋白质的水解度变化
Fig.6 Degree of milk protein hydrolysis during in vitro digestion under simulated elderly gastrointestinal conditions
胃消化全程所有牛奶样品的蛋白质水解率无显著差异,胃消化结束时,水解率均在5%~7%。肠消化阶段,所有SA-Milk的蛋白质水解速率均高于对照组牛奶,其中SA-Milk-15样品的水解率始终高于其他样品。消化终点数据显示:SA-Milk-15水解率最高(39.50±1.25)%,其后依次为SA-Milk-10(35.33±1.43)%、SA-Milk-5(33.85±1.65)%和SA-Milk-20(32.64±1.55)%,对照组最低(29.31±0.94)%。该质量浓度响应趋势与样品黏度变化高度吻合,蛋白质水解率随SA质量浓度增加呈先升后降的非线性变化规律,其内在机制与流变特性直接关联:在低质量浓度区间(<15 mg/mL),SA通过静电排斥作用抑制蛋白质聚集,降低体系黏度,减少胃消化阶段的空间位阻效应,从而提升酶与底物的接触效率[7,23];当质量浓度超过临界阈值(≥15 mg/mL)时,SA分子链缠结密度增加,且与钙离子构建的弱凝胶结构显著增加体系黏度,限制了酶的扩散以及酶与底物的作用[7]。
综上所述,在模拟老年人体外消化条件下,消化终点牛奶蛋白的水解率并未随SA质量浓度的增加呈单调上升趋势,而是存在一个蛋白质水解率达到峰值的最佳SA质量浓度阈值。本研究结果表明,在SA质量浓度为0~20 mg/mL时,添加15 mg/mL SA的样品表现出最高的蛋白质消化率。
3 结论与讨论
本研究表明,在模拟老年胃肠条件下,SA通过调节胃蛋白凝乳特性和体系黏度,显著影响牛奶蛋白的消化行为。当SA质量浓度为0~15 mg/mL时,可促进形成质量更小、粒径更低的碎片化凝乳,增强酶的可及性,使蛋白水解率随质量浓度升高而提高[对照牛奶:(29.31±0.94)% [1] JIANG Q B, FENG Q S.Editorial:Aging and health in China[J].Frontiers in Public Health, 2022, 10:998769. [2] DUIJSENS D, VERKEMPINCK S H E, SOMERS E, et al.From static to semi-dynamic in vitro digestion conditions relevant for the older population:Starch and protein digestion of cooked lentils[J].Food &Function, 2024, 15(2):591-607. [3] FU J X, ZHENG Y, GAO Y, et al.Dietary fiber intake and gut microbiota in human health[J].Microorganisms, 2022, 10(12):2507. [4] YU D M, ZHAO L Y, ZHAO W H.Status and trends in consumption of grains and dietary fiber among Chinese adults (1982-2015)[J].Nutrition Reviews, 2020, 78(Suppl 1):43-53. [5] SNAUWAERT E, PAGLIALONGA F, VANDE WALLE J, et al.The benefits of dietary fiber:The gastrointestinal tract and beyond[J].Pediatric Nephrology, 2023, 38(9):2929-2938. [6] REYNOLDS A N, AKERMAN A, KUMAR S, et al.Dietary fibre in hypertension and cardiovascular disease management:Systematic review and meta-analyses[J].BMC Medicine, 2022, 20(1):139. [7] QIN D K, YANG X J, GAO S R, et al.Influence of hydrocolloids (dietary fibers) on lipid digestion of protein-stabilized emulsions:Comparison of neutral, anionic, and cationic polysaccharides[J].Journal of Food Science, 2016, 81(7):C1636-C1645. [8] ZHANG L N, LIANG R W, LI L.The interaction between anionic polysaccharides and legume protein and their influence mechanism on emulsion stability[J].Food Hydrocolloids, 2022, 131:107814. [9] SHI F F, CHANG Y G, SHEN J J, et al.A comparative investigation of anionic polysaccharides (sulfated Fucan, ι-carrageenan, κ-carrageenan, and alginate) on the fabrication, stability, rheology, and digestion of multilayer emulsion[J].Food Hydrocolloids, 2023, 134:108081. [10] ZHANG P, IQBAL S, DENG R P, et al.Impact of elderly gastrointestinal alterations on gastric emptying and enzymatic hydrolysis of skim milk:An in vitro study using a dynamic stomach system[J].Food Chemistry, 2023, 402:134365. [11] MENARD O, LESMES U, SHANI-LEVI C S, et al.Static in vitro digestion model adapted to the general older adult population:An INFOGEST international consensus[J].Food &Function, 2023, 14(10):4569-4582. [12] LEVI C S, LESMES U.Bi-compartmental elderly or adult dynamic digestion models applied to interrogate protein digestibility[J].Food &Function, 2014, 5(10):2402-2409. [13] BRODKORB A, EGGER L, ALMINGER M, et al.INFOGEST static in vitro simulation of gastrointestinal food digestion[J].Nature Protocols, 2019, 14(4):991-1014. [14] YE A Q, LIU W L, CUI J, et al.Coagulation behaviour of milk under gastric digestion:Effect of pasteurization and ultra-high temperature treatment[J].Food Chemistry, 2019, 286:216-225. [15] JALABERT-MALBOS M L, MISHELLANY-DUTOUR A, WODA A, et al.Particle size distribution in the food bolus after mastication of natural foods[J].Food Quality and Preference, 2007, 18(5):803-812. [16] IQBAL S, ZHANG P, WU P, et al.Modulation of viscosity, microstructure and lipolysis of W/O emulsions by cellulose ethers during in vitro digestion in the dynamic and semi-dynamic gastrointestinal models[J].Food Hydrocolloids, 2022, 128:107584. [17] COFRADES S, GARCIMART [18] HU Z J, WU P, WANG L P, et al.Exploring in vitro release and digestion of commercial DHA microcapsules from algae oil and tuna oil with whey protein and casein as wall materials[J].Food &Function, 2022, 13(2):978-989. [19] NIELSEN P M, PETERSEN D, DAMBMANN C.Improved method for determining food protein degree of hydrolysis[J].Journal of Food Science, 2001, 66(5):642-646. [20] SPELLMAN D, MCEVOY E, O’CUINN G, et al.Proteinase and exopeptidase hydrolysis of whey protein:Comparison of the TNBS, OPA and pH stat methods for quantification of degree of hydrolysis[J].International Dairy Journal, 2003, 13(6):447-453. [21] HORSTMAN A M H, HUPPERTZ T.Milk proteins:Processing, gastric coagulation, amino acid availability and muscle protein synthesis[J].Critical Reviews in Food Science and Nutrition, 2023, 63(30):10267-10282. [22] YANG M X, YE A Q, YANG Z, et al.Probing structural modification of milk proteins in the presence of pepsin and/or acid using small- and ultra-small-angle neutron scattering[J].Food Hydrocolloids, 2025, 159:110681. [23] HU M, GAO Y X, WEN W, et al.The aggregation behavior between soybean whey protein and polysaccharides of diverse structures and their implications in soybean isoflavone delivery[J].Food Chemistry, 2024, 439:138061. [24] AALAEI K, KHAKIMOV B, DE GOBBA C, et al.Digestion patterns of proteins in pasteurized and ultra-high temperature milk using in vitro gastric models of adult and elderly[J].Journal of Food Engineering, 2021, 292:110305. [25] 张席锦, 陈元方.糖、蛋白质和脂类的消化和吸收[J].中华消化杂志, 1997, 17(2):103-105.ZHANG X J, CHEN Y F.Digestion and absorption of sugar, protein and lipids[J].Chinese Journal of Digestion, 1997, 17(2):103-105. N A, PÉREZ-MATEOS M, et al.Stabilized soy protein emulsion enriched with silicon and containing or not methylcellulose as novel technological alternatives to reduce animal fat digestion[J].Food Research International, 2023, 170:112833.
N A, PÉREZ-MATEOS M, et al.Stabilized soy protein emulsion enriched with silicon and containing or not methylcellulose as novel technological alternatives to reduce animal fat digestion[J].Food Research International, 2023, 170:112833.